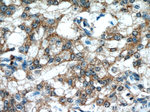
PRDX4 Antibody in Immunohistochemistry (Paraffin) (IHC (P))

Search
Proteintech
PRDX4 Monoclonal Antibody (5B6F1)
{{$productOrderCtrl.translations['antibody.pdp.commerceCard.promotion.promotions']}}
{{$productOrderCtrl.translations['antibody.pdp.commerceCard.promotion.viewpromo']}}
{{$productOrderCtrl.translations['antibody.pdp.commerceCard.promotion.promocode']}}: {{promo.promoCode}} {{promo.promoTitle}} {{promo.promoDescription}}. {{$productOrderCtrl.translations['antibody.pdp.commerceCard.promotion.learnmore']}}
产品信息
60286-1-IG
种属反应
宿主/亚型
分类
类型
克隆号
抗原
偶联物
形式
浓度
规格
纯化类型
保存液
内含物
保存条件
运输条件
产品详细信息
Immunogen sequence: MEALPLLAA TTPDHGRHRR LLLLPLLLFL LPAGAVQGWE TEERPRTREE ECHFYAGGQV YPGEASRVSV ADHSLHLSKA KISKPAPYWE GTAVIDGEFK ELKLTDYRGK YLVFFFYPLD FTFVCPTEII AFGDRLEEFR SINTEVVACS VDSQFTHLAW INTPRRQGGL GPIRIPLLSD LTHQISKDYG VYLEDSGHTL RGLFIIDDKG ILRQITLNDL PVGRSVDETL RLVQAFQYTD KHGEVCPAGW KPGSETIIPD PAGKLKYFDK LN (1-271 aa encoded by BC007107)
靶标信息
Peroxiredoxin (Prx) is a growing peroxidase family, whose mammalian members have been known to connect with cell proliferation, differentiation, and apoptosis. Many isoforms (about 50 proteins), collected in accordance to the amino acid sequence homology, containing active site cysteine residue, and the thiol-specific antioxidant activity, distribute throughout all the kingdoms. Among them, mammalian Prx consists of 6 different members grouped into typical 2-Cys, atypical 2-Cys Prx, and 1-Cys Prx. Except Prx VI belonging to 1-Cys Prx subgroup, the other five 2-Cys Prx isotypes have the thioredoxin-dependent peroxidase (TPx) activity utilizing thioredoxin, thioredoxin reductase, and NADPH as a reducing system. Mammalian Prxs are 20-30 kilodalton in molecular size and vary in subcellular localization: Prx I, II, and VI in cytosol, Prx III in mitochondria, Prx IV in ER and secretion, Prx V showing complicated distribution including peroxisome, mitochondria and cytosol.
仅用于科研。不用于诊断过程。未经明确授权不得转售。
生物信息学
蛋白别名: Antioxidant enzyme AOE372; AOE37-2; EC 1.11.1.15; epididymis secretory sperm binding protein Li 97n; Peroxiredoxin IV; Peroxiredoxin-4; PRDX4; Prx 4; Prx IV; Prx-IV; Thioredoxin dependent peroxide reductase A0372; thioredoxin peroxidase (antioxidant enzyme); Thioredoxin peroxidase AO372; Thioredoxin-dependent peroxide reductase A0372; Thioredoxin-dependent peroxiredoxin 4
基因别名: AOE37-2; AOE372; HEL-S-97n; PRDX4; PRX-4; Prx-iv; Prx4; Rno2CysPrx04; TRANK
UniProt ID: (Human) Q13162, (Rat) Q9Z0V5, (Mouse) O08807
Entrez Gene ID: (Human) 10549, (Rat) 85274, (Mouse) 53381